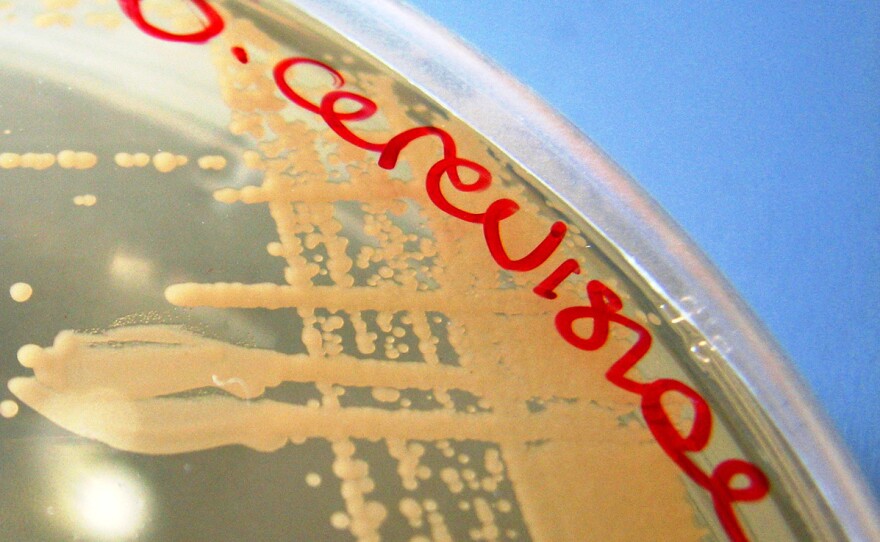

A humble creature that has long toiled in obscurity for the benefit of humankind is poised to win a small measure of the distinction it deserves: designation as Oregon's official state microbe.
It looks to be the first microbe to gain official state recognition.
The microbe in question, Saccharomyces cerevisiae, plays a key role in the state's economy. Without it, sugar would not become alcohol, and Oregon would not have a craft beer industry worth $2.4 billion.
That's a lot of yeast.
The man behind the yeast's pending glamour moment is Mark Johnson, a Republican state legislator from Hood River, Ore. The idea, he says, came from a home-brewing constituent, who suggested that the legislature -- which has already designated a state nut (hazelnut) and a state fruit (pear) -- do the right thing by another living embodiment of Oregon's contribution to quality foodstuffs.
"It seemed like a good thing to proclaim Saccharomyces cerevisiae the state microbe," Johnson told The Salt.
The microbe's name came trippingly off his tongue. How long did it take him to memorize it? The lawmaker laughs. "You know, I have to keep a cheat sheet in front of me with the phonetics written out."
But it turns out that Johnson has done his homework on Saccharomyces cerevisiae and its role in the Beaver State's enviable lifestyle.
"I'm an IPA guy," he proclaims. "The more hops I can have in a beer, the better."
He's in luck there. Johnson's district is home to Full Sail, makers of some nice, hoppy brews, as well as four or five smaller breweries started by former employees.
Oregon ranks third in the nation in the number of craft brewers, according to the Oregon Brewer's Guild, which claims that Portland has more breweries than any other city in the world.
Not only that. Brewer's yeast is indispensable not just in brewing beer, but in making bread, cheese, and craft distilled spirits, all popular Oregon items. "It's the bedrock of a lot of fun and enjoyable products," Johnson says.
When the vote came to committee this week, several fellow lawmakers worried that they might be unfairly favoring one microbe over another.
"Is there any other microbe that anybody else likes better than this one that is in competition with your microbe?" asked Rep. Vicki Berger of Salem, according to TheOregonian.
"I'm not aware of any other microbes that generate $2.4 billion for the state economy," Johnson responded.
The measure passed the House Rules Committee unanimously, and is headed for a vote in the full Oregon House next week.
We at The Salt are longtime fans of Saccharomyces cerevisiae.Our resident bard, Adam Cole, sang the praises of this humblest of all beasts in a St. Patrick's Day tribute, which is definitely worth a view.
And Lydia Zuraw chronicled how brewers strive to make those finicky beasties happy. Because when the Saccharomyces cerevisiae is happy, we're all happy.
Copyright 2013 NPR. To see more, visit www.npr.org.